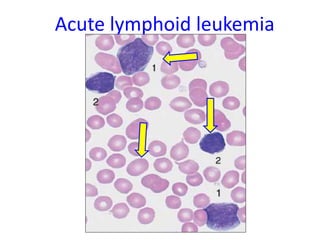
Acute lymphoid leukemia
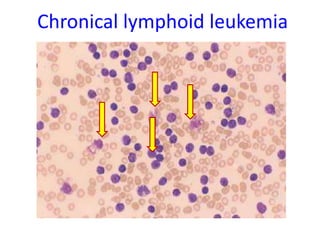
Chronical lymphoid leukemia
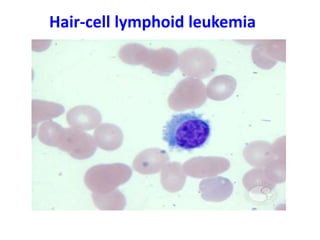
Hair-cell lymphoid leukemia

The document discusses the pathology of leukocytes and leukemia, covering quantitative and qualitative disorders of leukocytes, their classifications, and the underlying etiologies and mechanisms involved. It highlights both leukocytosis and leukopenia, detailing the causes and types alongside the distinction between acute and chronic leukemia, and their respective clinical features. The document also addresses the genetic and environmental factors that contribute to leukemic transformations, including chromosomal aberrations and viral influences.